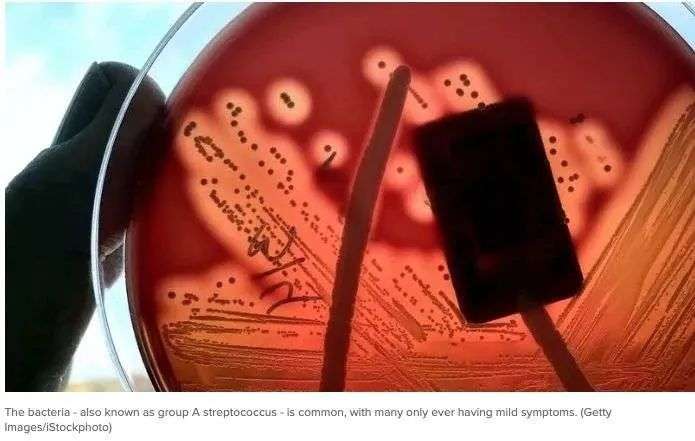

收藏
收藏澳洲爆发细菌感染,死亡人数激增,上千人确诊,药物严重短缺!多州紧急发警告!
上个月印象君报道了英国突发数百例细菌感染病例,截止至去年就已有60人死亡。
英国当地媒体报道称,自9月中旬以来,至少有30名儿童死亡。
而这种致命病毒就是侵袭性A组链球菌。

但随着新年来临,澳洲的A型链球菌的感染也在急剧增多!
澳洲多地卫生部纷纷发出紧急警告!死亡人数也在激增!
更令人担忧的事,在这个节骨眼上,澳洲的抗生素不够用了...

世界范围内病例都在激增
澳洲医学专家呼吁人们要注意感染A型链球菌后的临床症状,因为如今与A型链球菌感染相关的死亡人数正在激增。

根据国家法定疾病监测系统,2022年全澳大利亚有1000多例严重侵袭性链球菌感染病例。

格里菲斯大学糖系研究所的Michael Good教授说,“突然增加”的原因尚不清楚。
他说,这似乎不是一个正在传播的新菌株,它不是澳洲独有的,我的同事们在加拿大和英国也看到了它。
Good教授说,这可能是因为我们看到了其他的更多病毒,这些病毒与链球菌一起感染可以使疾病更加严重。
2022年12月,世界卫生组织表示,包括英国、法国、爱尔兰、瑞典和荷兰在内的国家也报告了iGAS和猩红热病例的增加。
Good教授说,“世界是一个地球村”,澳洲的iGAS和猩红热病例可能会在今年冬天上升。

什么是A组链球菌?
Group A Streptococcus (Group A Strep或Strep A)可引起多种不同的感染。
这种细菌通常在喉咙和皮肤上发现,有些人没有症状。
Strep A引起的感染范围从轻微疾病到严重和致命。
它们包括皮肤感染脓疱病、猩红热和链球菌性咽喉炎。
虽然绝大多数感染都相对轻微,但有时这种细菌会导致一种称为侵袭性A群链球菌病的疾病。

什么是侵袭性A组链球菌病?
侵袭性A组链球菌病有时是一种危及生命的感染,其中细菌侵入了身体的某些部位,如血液、深层肌肉或肺部。
当细菌侵入身体的某些部位,如血液、深层肌肉或肺部时,就会出现iGAS并发症。
两种最严重但罕见的侵袭性疾病是坏死性筋膜炎和链球菌毒性休克综合征。

坏死性筋膜炎也被称为“食肉菌”,如果伤口受到感染,就会发生。
链球菌中毒性休克综合征是一种进展迅速的感染,导致低血压/休克,并损害肾脏、肝脏和肺部等器官。
这种中毒性休克的死亡率很高。
新州感染病例增加
卫生部呼吁各界关注
1月6日,新州卫生部建议社会各界关注细菌感染患者的症状和体征,最近细菌感染的病例数量有所增加。

新州健康保护执行主任理Richard Broome博士说,最近几周,脑膜炎球菌病(IMD)和侵袭性A群链球菌(iGAS)感染患者都有所增加。
到2022年底,新州的IMD病例远高于平均水平,新州、其他州和海外的iGAS病例都有所增加。
Broome说,尽管这两种细菌感染非常罕见,但他们的发病症状非常严重,可能导致死亡或永久性残疾。
“IMD或iGAS细菌感染的早期阶段表现出是症状类似新冠或其他流感。”
“及时对侵入性细菌感染进行干预与治疗能够成功拯救患者的生命。出现类似症状的患者可以随时关注自己的身体状况,一旦症状恶化请在第一时间前往就医。”
“虽然新州最近才有关于iGAS的数据通报,但世界各地的患者数量正在呈增加趋势。”
2022年9月至12月期间,新州通报了137例iGAS病例。

2022年新州报告了36例脑膜炎球菌病(IMD)。
有关iGAS和IMD的更多信息,请参阅新州卫生网站的公告。
新州卫生部也提示:如果担心自己或孩子的健康,可致电全科医生或HealthDirect,电话:1800 022 222。
如果自己或周围人出现严重不适,应及时拨打000。
维州两名儿童死亡
医院拉响警报
在同一天,维州卫生当局和专家也发出警告,儿童Strep A感染的数量将激增。

维州医院安全监督机构Safer Care Victoria上个月发布的一份警报称,2022年,皇家儿童医院(RCH)和莫纳什儿童医院检测到42例侵袭性链球菌A感染病例。
去年,维州有2个孩子死于这种疾病。超60人需住院治疗,许多儿童需要重症监护。

通知称:“自9月以来,RCH确定的侵袭性A组链球菌感染的数量……与平均每年(每年20-25例)的数量相似(21例)。”
默多克儿童研究所的儿科传染病研究人员安德鲁·斯蒂尔教授告诉澳大利亚广播公司ABC Radio,侵入性感染的迹象“相对不明确”。
社交活动增加、免疫力下降可能是激增的原因。

他说,虽然没有必要恐慌,但父母应该关注孩子的症状。
斯蒂尔教授表示,每年大约有四分之一的儿童出现“链球菌性咽喉炎”的轻微症状。
他说:“喉咙痛很常见,侵袭性感染很少见,所以我认为这非常重要。”
斯蒂尔教授表示,病例数的上升可能是一系列因素造成的,包括疫情封锁后社交活动的增加、社区成员免疫力的降低以及新毒株的可能出现。

昆州感染率上升30%
已有9人死亡
2022年仅昆州便有9人死于A型链球菌感染,感染率上升了30%。

去年9月,昆州的一家人在前往K‘gari(弗雷泽岛)旅行时突然病倒。
保罗·伯克特(Paul Burkett)在医院度过了11天才从感染中康复,这趟旅行让他和十几岁的儿子都病得很重。
伯克特说,他一开始是感到不舒服,然后注意到自已手上在钓鱼时不小心的划的伤口已经被感染,随后他便开始感觉到身体很冷。

不幸的是,他年迈的岳父死于感染引起的并发症而去世。

伯克特在出现Strep A感染后进行了三次手术来清理肘部、拇指和手指。

昆士兰卫生部的一位发言人表示,任何有症状的人如果怀疑自己可能感染了这种疾病,都应该立即就医。
传染病专家Paul Griffin博士告诉《今日报》,虽然这种细菌“并非特别罕见” ,但它可能会导致儿童或老人等弱势群体患上严重疾病。

他说:“我们目前真正需要做到的是提高人们的防范意识,因为我们其实拥有可以产生巨大效应的抗生素。”
“这就是为什么我们说的,需要人们了解症状是什么样子,以便感染者能够及时寻求帮助。”
常见症状包括:急性喉咙痛、吞咽痛感、发烧、扁桃体红肿,有时伴有白色斑块或条状脓液,以及口腔顶部出现小红点。

所有产生上述症状的人都应立即联系GP。
全澳抗生素紧缺
呼吁人们提高防范意识的同时,澳洲也在努力应对抗生素短缺问题。

Griffin博士说:“这并不是说我们没有抗生素来治疗此类感染,但我们现在不得不使用二线抗生素,这种抗生素更复杂,具有不必要的广谱性同时更加昂贵。”
“这对我们来说是个大问题,我再次强调我们的确需要解决这个问题,希望监管部门可以考虑在当地制造像这样重要的药物。”
目前,全澳常规抗生素供应紧缺成为了澳洲公众面对的一个难题。

据 Sydney Morning Herald报道,全澳有361种药物被限量供应,其中45中是公众常用药物。
儿童液体抗生素尤为紧缺。

很多公众在对用抗生素极度需要的情况下,不得已求助于药剂师。药剂师常常会迫于病人压力,而使用其他药物来满足患者。
抗生素的紧缺是由于患者对其极高的需求所造成的,并且将持续数月之久。
澳大利亚医学协会(Australian Medical Association )提醒,患者应首选国产药物。
Therapeutic Goods Association 上月发布的通知表示,将允许药剂师使用其他相关药物来替代需要处方的口服阿莫西林,以帮助患者减缓病痛。
“这是一种广泛使用的抗生素,可以用于治疗许多不同的细菌感染。”
TGA(Therapeutic Goods Association)还表示,抗生素的短缺,是由于一家药品主要供应商出现的“制造问题”所导致的。
MAM(Australian Medical Association )副主席 Danielle McMullen 表示,该组织呼吁全澳公众尽量将口服抗生素留给为儿童、老人和吞咽困难的患者。
她还表示,抗生素的紧缺也提醒澳洲有关部门应大力发展国产药物的生产于制造,而不是依赖国际供应。
印象结语
自去年下半年以来,世界各国的Strep A感染激增,不仅大人们在苦苦斗争,不幸的是,还有许多儿童丧命。
目前澳洲却又出现抗生素紧缺的问题,治疗过程也面临挑战。
印象君提醒,近期节日来临,人流量加大,而且澳洲正值夏季,大家纷纷前往海边消暑,一定要注意个人卫生以及不要轻视任何身体上的开放性伤口。一旦感到不适或出现上述症状,一定要及时就医。
原创声明:本文系本站原创采写,未获本站书面授权严禁转载!在获授权前提下,转载必须在醒目位置注明本文出处和具体网页链接。对未注明而擅自转载者,本站保留追究法律责任的权利。

































你需要登录后才能评论 登录